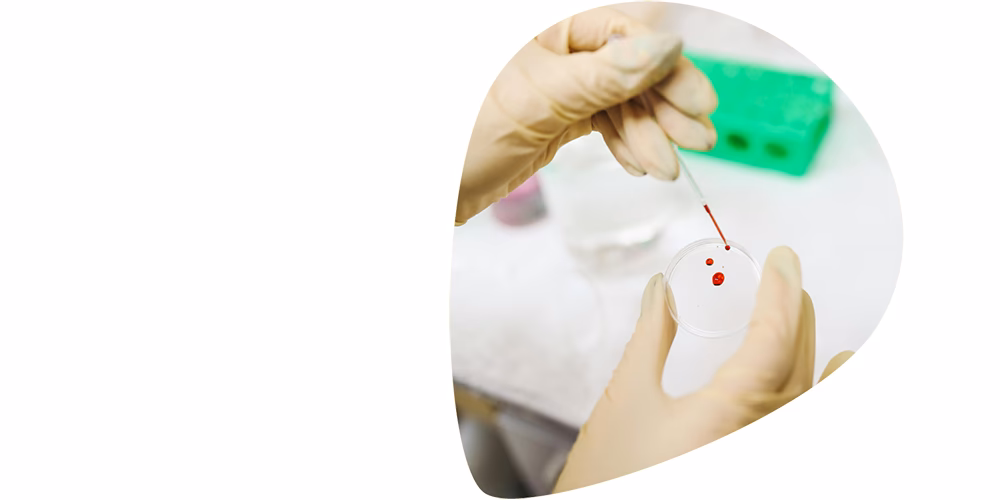
Is there a compensation scheme for the contaminated blood scandal?

26/10/2019
El Reino Unido enfrenta uno de los capítulos más oscuros de su historia sanitaria: el escándalo de la sangre infectada. Durante las décadas de 1970 y 1980, más de 30,000 personas fueron infectadas con virus mortales como el VIH y la Hepatitis C a través de productos sanguíneos contaminados suministrados por el Servicio Nacional de Salud (NHS). Tras décadas de lucha y sufrimiento, una investigación pública ha arrojado luz sobre la tragedia y ha impulsado la creación de un Esquema de Compensación por Sangre Infectada. Este artículo desglosa en detalle qué fue este escándalo, cómo ocurrió y, lo más importante, cómo funciona el programa de compensación para las víctimas y sus familias.

¿Qué fue el Escándalo de la Sangre Infectada?
Esta tragedia afectó principalmente a dos grupos de pacientes. El primero estaba compuesto por personas con hemofilia, un trastorno genético que impide la coagulación adecuada de la sangre. En la década de 1970, se desarrolló un nuevo tratamiento revolucionario llamado Factor VIII, un concentrado de proteínas de coagulación obtenido del plasma sanguíneo de donantes. Sin embargo, para producir un solo lote se requería el plasma de miles de donantes, y si uno solo de ellos estaba infectado, todo el lote se contaminaba. El segundo grupo afectado fueron pacientes que recibieron transfusiones de sangre contaminada después de cirugías, tratamientos médicos o partos entre 1970 y 1991.
La escala de la catástrofe es abrumadora. La investigación estima que 1,250 personas con trastornos hemorrágicos fueron infectadas tanto con VIH como con Hepatitis C, siendo casi un tercio de ellos niños. Trágicamente, dos tercios de este grupo murieron más tarde por enfermedades relacionadas con el SIDA. Además, se estima que entre 2,400 y 5,000 hemofílicos desarrollaron únicamente Hepatitis C. Para el grupo de receptores de transfusiones, se calcula que entre 80 y 100 personas fueron infectadas con VIH y unas 27,000 con Hepatitis C. La Haemophilia Society estima que más de 3,000 vidas se han perdido a causa de esta negligencia.

El Origen de la Contaminación: Una Cadena de Fallos
En la década de 1970, el Reino Unido no era autosuficiente en donaciones de sangre, lo que obligó al gobierno a importar grandes cantidades de Factor VIII, principalmente de Estados Unidos. Una parte significativa de este plasma provenía de donantes de alto riesgo, como reclusos de prisiones y consumidores de drogas, a quienes se les pagaba por su sangre. Al mezclar el plasma de miles de estas donaciones, el riesgo de contaminación viral se multiplicó exponencialmente.
Las alarmas no tardaron en sonar. A mediados de los 70 ya existían advertencias claras sobre el riesgo de infección viral en los productos sanguíneos importados. Sin embargo, los esfuerzos del Reino Unido por lograr la autosuficiencia fracasaron y se continuó utilizando sangre donada de alto riesgo. No fue hasta 1985 que todos los productos de Factor VIII comenzaron a ser tratados con calor para inactivar el virus del VIH, y las donaciones de sangre en el Reino Unido no se sometieron a pruebas de detección de Hepatitis C de forma rutinaria hasta 1991.
La Investigación Pública y el Esquema de Compensación
Tras años de incansable campaña por parte de las víctimas y sus familias, en 2017 se estableció la Investigación de Sangre Infectada, presidida por Sir Brian Langstaff. Su objetivo era examinar las circunstancias del escándalo, determinar responsabilidades y esclarecer si hubo intentos de encubrimiento por parte de las autoridades. La investigación ha sido demoledora, revelando fallos sistémicos y una falta de acción que costó miles de vidas.

Como resultado directo de las recomendaciones de la investigación, se ha establecido la Autoridad de Compensación por Sangre Infectada (IBCA, por sus siglas en inglés) para administrar los pagos a las víctimas. Este esquema busca proporcionar una reparación financiera por el inmenso daño físico, emocional y económico sufrido.
¿Quién es Elegible para el Esquema de Compensación?
Una persona califica para el esquema si es:
- Una persona infectada directamente: Alguien que, a través del uso de sangre, productos sanguíneos o tejidos suministrados por el NHS, fue infectado con VIH, Hepatitis C (aguda o crónica) o Hepatitis B (crónica).
- Una persona infectada indirectamente: Alguien que fue infectado por transmisión de una persona directamente infectada (por ejemplo, una pareja infectada por su compañero) o por alguien que a su vez fue infectado indirectamente (por ejemplo, un hijo infectado por su madre).
Es importante destacar que incluso si una persona se ha recuperado o su infección ha desaparecido, sigue siendo elegible para solicitar una compensación. El esquema no tiene fechas de corte estrictas, aunque los requisitos de evidencia son más altos para infecciones adquiridas después de la introducción de los métodos de detección.
Detalles de las Compensaciones: Un Vistazo a las Cifras
El esquema de compensación se estructura en diferentes categorías para reflejar los múltiples impactos del escándalo en la vida de una persona. A continuación, se presenta una tabla resumen de las adjudicaciones disponibles.
Tabla Comparativa de Compensaciones
| Categoría de Premio | Montos de la Ruta Principal | ¿Ruta Suplementaria disponible? |
|---|---|---|
| Lesión (Injury) | Hepatitis C Aguda: £10,000 Otras bandas de severidad: £60,000 - £270,000 | No |
| Impacto Social | Hepatitis C Aguda: £5,000 Otras bandas de severidad: £50,000 - £70,000 | No |
| Autonomía | Hepatitis C Aguda: £10,000 Otras bandas de severidad: £40,000 - £70,000 | Sí, si fue víctima de investigación no ética. |
| Cuidado (Care) | Hepatitis C Aguda: £500 Otras bandas de severidad: Aprox. £50,000 - £680,000 | Sí, para costos de cuidado más altos. |
| Pérdida Financiera | Hepatitis C Aguda: £12,500 Otras bandas de severidad: £5,931 - £29,657 por año | Sí, para pérdidas financieras más altas. |
Premios Suplementarios Disponibles
Además de las compensaciones principales, existen tres premios suplementarios para casos específicos:
- Premio de Autonomía por Investigación no Ética: Se otorgan premios adicionales (£10,000 o £15,000) para reconocer el sufrimiento de las víctimas sometidas a prácticas de investigación poco éticas, como los estudios del Dr. Craske o los realizados en el Lord Mayor Treloar College.
- Premio por Condición de Salud Grave: Compensación adicional para personas infectadas que han sufrido una condición de salud rara y severa como resultado de su infección o tratamiento, más allá de lo cubierto por la ruta principal.
- Premio por Pérdida Excepcional: Para víctimas que han sido afectadas financieramente de manera más significativa de lo que compensa la ruta principal, ya sea por haber tenido ingresos particularmente altos antes de la infección o por haber incurrido en altos costos de cuidado pagado.
Preguntas Frecuentes (FAQs)
- ¿Qué sucede si una persona infectada ya ha fallecido?
- Las nuevas reglas del esquema permiten que los herederos (estates) de las personas afectadas que ya han fallecido puedan reclamar una compensación en su nombre.
- ¿Cómo se pagan las compensaciones?
- La compensación puede pagarse como una suma global única o a través de una serie de pagos regulares (a plazos) durante 5, 10 o 25 años. Estos pagos se ajustarán anualmente según el Índice de Precios al Consumidor (IPC).
- ¿Afectarán estos pagos a mis beneficios sociales o impuestos?
- No. Los pagos de compensación realizados a través del esquema están exentos de afectar las prestaciones sociales basadas en los ingresos y también están exentos del impuesto sobre la renta, las ganancias de capital y el impuesto de sucesiones.
- ¿Qué es el concepto de "retorno al esquema"?
- Si la salud de una persona infectada se deteriora significativamente, cambiando su banda de severidad de infección o desarrollando una nueva condición grave, puede ser elegible para una reevaluación y una compensación adicional. Esto se conoce como "retorno al esquema".
- ¿Los beneficiarios actuales de los Esquemas de Apoyo a la Sangre Infectada (IBSS) son elegibles?
- Sí, todas las personas infectadas que son beneficiarias de un IBSS serán consideradas automáticamente elegibles para el esquema de compensación. Podrán optar por continuar recibiendo sus pagos de apoyo de por vida, y la nueva compensación se ajustará en consecuencia.
El escándalo de la sangre infectada es una herida profunda en la conciencia nacional del Reino Unido. Representa un fallo catastrófico del estado en su deber más fundamental: proteger a sus ciudadanos. Aunque ninguna cantidad de dinero puede devolver las vidas perdidas o borrar décadas de dolor, el Esquema de Compensación por Sangre Infectada es un paso crucial y largamente esperado hacia el reconocimiento, la justicia y la reparación para miles de víctimas y sus familias.
Si quieres conocer otros artículos parecidos a Escándalo Sangre Infectada: Guía de Compensación puedes visitar la categoría Ecología.
